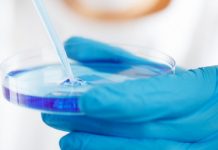

이 콘텐츠는 사이트 회원 전용입니다. 기존의 사용자라면 로그인 하세요. 새 사용자는 아래에서 회원가입 할 수 있습니다.
망막박리, 백내장 등 시력 저하와 손실을 유발하는 요인은 여러 가지가 있을 수 있다. 유니버시티 칼리지 런던(University College London)의 안과 의사 리차드 리(Richard Lee) 박사 연구팀은 특정 유전성 안과 질환으로 인한 시력 저하가 장내 세균에 의해 유발될 수 있다는 사실을 밝혀냈다. 이 연구 결과(논문명: CRB1-associated retinal degeneration is dependent on bacterial


























![[보고서] 딥씨크 출현과 한국 AI 미래전략](http://ww.itnews.or.kr/wp-content/uploads/2025/02/7-218x150.png)

![[2024 애플 동향] ③ 애플카 ‘프로젝트 타이탄’의 실패 원인](http://ww.itnews.or.kr/wp-content/uploads/2024/03/1-2-218x150.png)
![[2024 애플 동향] ② 애플카 ‘프로젝트 타이탄’ 10년간 의 여정](http://ww.itnews.or.kr/wp-content/uploads/2024/03/4-218x150.png)
![[2024 애플 동향] ① 애플 프로젝트 타이탄’ 종료](http://ww.itnews.or.kr/wp-content/uploads/2024/03/Midjourney-218x150.png)